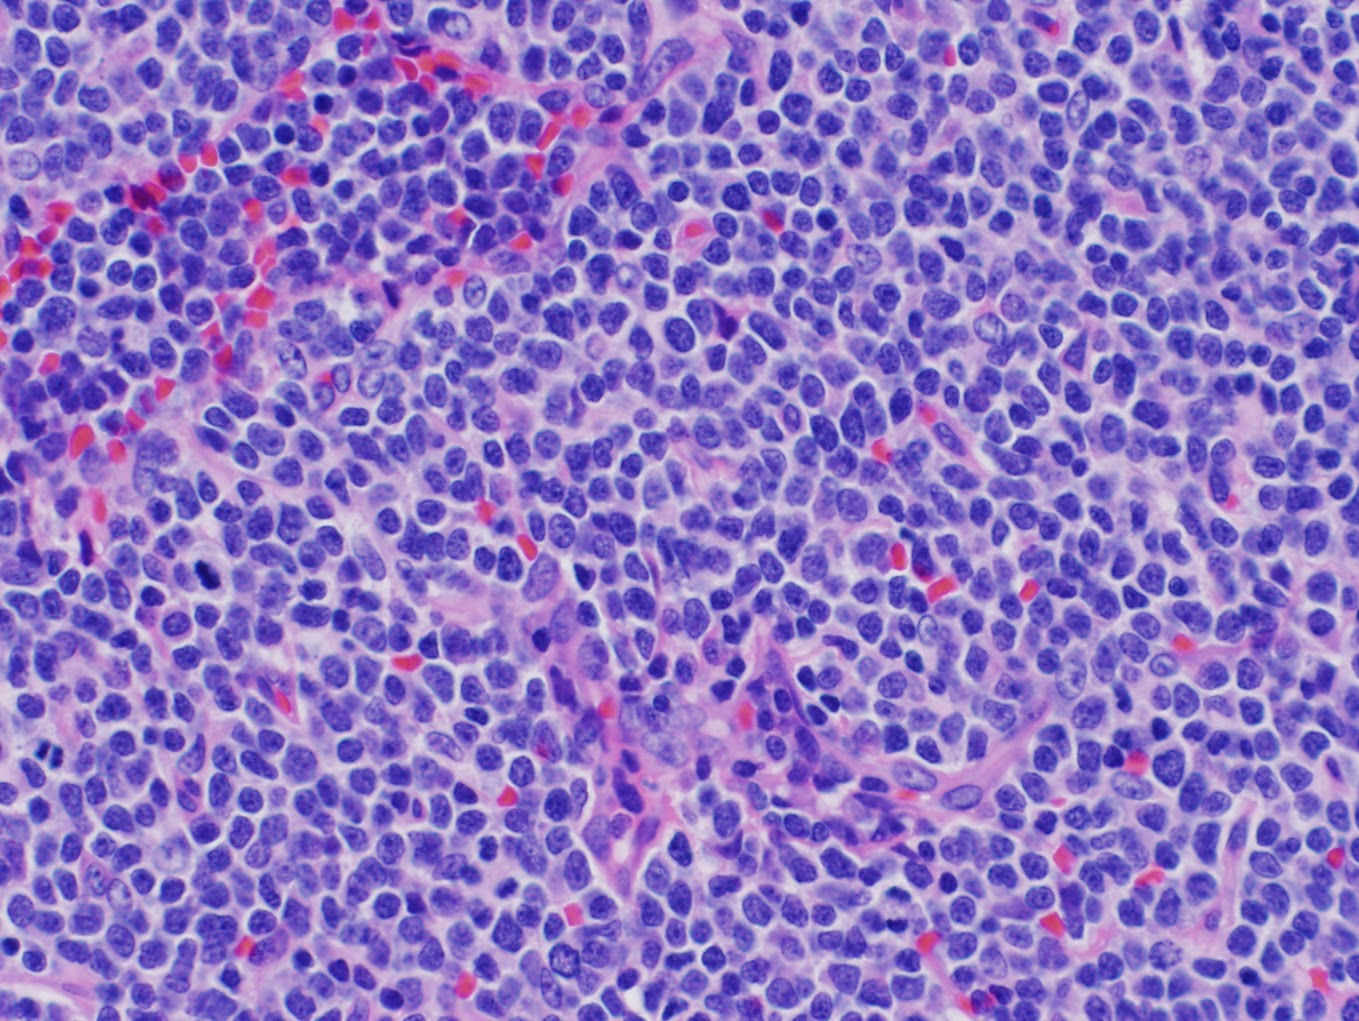

HAPPY BIRTHDAY DILLON JACE!!!

Thursday, May 31, 2012
Wednesday, May 30, 2012
Adjustments
Wednesday, May 30, 2012
Today showed me what a huge adjustment we are all needing to make. I found myself thinking at one point...."I cannot wait for things to be normal again." Then I realized that things are changed...FOREVER.
D's biggest struggles today were taking his pills. He has to take 7 pills twice a day. He just recently learned how to swallow his tiny little allergy pill and now he has to chug down enormous amounts of water and juice to get his pile of pills down. This usually leads to gagging, occasional vomiting, tears, bloated cramped stomach, frustration, and fear. I am scouring the internet for more ideas on how to make this easier. I have located a product that is a flavored spray gel. You coat the mouth so you taste the flavoring instead of the pill and then supposedly the pill just slides down instead of sticking and beginning to melt on the tongue. I cannot decide if I should buy it or just keep on cheering Big D on in the hopes that he will learn a magic technique that works for him. Maybe he will "get used to it."
People keep saying that....."He will get used to it." Really, do you think so...a 10-year-old boy will get used to feeling lousy, nauseous, exhausted, anxious, unable and uninterested in playing, living around a schedule of doctor appointments, frustrated, scared, and angry....I THINK NOT!!!!
The Pickle did enthusiastically eat 3 meals today....not large meals but a semi-regular solid food consumption. I cannot tell you how distressing it is to see my child not able or willing to eat. Someone asked him what his favorite foods are the other day because they are making foods for our freezer so we don't have to cook, and the poor child could not come up with anything. His little brother was rattling off things that Dillon tends to enjoy, all the while Big D sort of scowling at the mere mention of food. So, today when he actually ASKED for lunch, I rejoiced.
The long road of adjusting to our "NEW NORMAL" has begun.
Today showed me what a huge adjustment we are all needing to make. I found myself thinking at one point...."I cannot wait for things to be normal again." Then I realized that things are changed...FOREVER.
D's biggest struggles today were taking his pills. He has to take 7 pills twice a day. He just recently learned how to swallow his tiny little allergy pill and now he has to chug down enormous amounts of water and juice to get his pile of pills down. This usually leads to gagging, occasional vomiting, tears, bloated cramped stomach, frustration, and fear. I am scouring the internet for more ideas on how to make this easier. I have located a product that is a flavored spray gel. You coat the mouth so you taste the flavoring instead of the pill and then supposedly the pill just slides down instead of sticking and beginning to melt on the tongue. I cannot decide if I should buy it or just keep on cheering Big D on in the hopes that he will learn a magic technique that works for him. Maybe he will "get used to it."
People keep saying that....."He will get used to it." Really, do you think so...a 10-year-old boy will get used to feeling lousy, nauseous, exhausted, anxious, unable and uninterested in playing, living around a schedule of doctor appointments, frustrated, scared, and angry....I THINK NOT!!!!
The Pickle did enthusiastically eat 3 meals today....not large meals but a semi-regular solid food consumption. I cannot tell you how distressing it is to see my child not able or willing to eat. Someone asked him what his favorite foods are the other day because they are making foods for our freezer so we don't have to cook, and the poor child could not come up with anything. His little brother was rattling off things that Dillon tends to enjoy, all the while Big D sort of scowling at the mere mention of food. So, today when he actually ASKED for lunch, I rejoiced.
The long road of adjusting to our "NEW NORMAL" has begun.
Benefit Recital
May 30, 2012
Re: Lucian & Phoenix Avalon Recital, Saturday, June 2, 4:00 PM, 528 Jose St., Santa Fe
NOW A BENEFIT FOR DILLON BUCKLEY
Dear Friends and Family:
Lucian and Phoenix Avalon will present their spring recital at 528 Jose St., Santa Fe, this weekend - Saturday, June 2, at 4:00 PM.
If you have not attended one of the Avalons' recitals, you have missed
a truly stunning experience, These kids are tops in technique AND
musicality. Many of us in the adult world wish we could play as well.
They will be joined by special guest Carmelo de los Santos, Professor
of Violin at UNM.
Lucian and Phoenix have graciously dedicated this concert to their fellow CHAMP, Dillon Buckley.
All proceeds will go to the Buckley family to support Dillon's treatment and recovery.
Please join us for this exceptional concert!
All proceeds will go to the Buckley family to support Dillon's treatment and recovery.
Please join us for this exceptional concert!
Gail Robertson
Champs Co-ordinator
505-660-1145
Tuesday, May 29, 2012
Home at Last
Tuesday, May 29, 2012
Big D and I are FINALLY home!!! That was the longest two weeks EVER!!!
I am, however, completely wiped out, so this is all the post you are getting for this evening.
I will add more later, just know that we are both so happy to be here, a bit anxious about our new tasks at home (meds, and side effects and appointments and paperwork) but we are grateful for the care D received and will be on to the next step of this adventure.
So grateful to be home before my boy's 11th birthday.
Farewell for now.....
Big D and I are FINALLY home!!! That was the longest two weeks EVER!!!
I am, however, completely wiped out, so this is all the post you are getting for this evening.
I will add more later, just know that we are both so happy to be here, a bit anxious about our new tasks at home (meds, and side effects and appointments and paperwork) but we are grateful for the care D received and will be on to the next step of this adventure.
So grateful to be home before my boy's 11th birthday.
Farewell for now.....
Sunday, May 27, 2012
Chemo #2
Sunday, May 27, 2012
Tomorrow is Big D's second round of chemotherapy. It is going to happen in the room while he is sedated because it includes the injection of some chemo into his spinal canal. He is nervous, of course, but more confidence is growing every day and the caveat of getting to go home either monday afternoon or Tuesday morning is overpowering the fear.
My brother and niece are here from Montana to lend a hand with Luca and Dill Pickle's care and entertainment.
I am so very extremely blessed with a loving, close-knit, supportive, involved, hands-on family.
GO TEAM D!!!!!
Today, Sunday is very quiet and calm around the unit. Half of the staff are at the Kids Cancer camp that happens every spring. There are not that many staff so it seems mellow. Dill Pickle is feeling well, more energy than yesterday for sure. He is eating and beginning to crave some foods (albeit not the most healthy choices but intake is intake at this point).
Tomorrow is Big D's second round of chemotherapy. It is going to happen in the room while he is sedated because it includes the injection of some chemo into his spinal canal. He is nervous, of course, but more confidence is growing every day and the caveat of getting to go home either monday afternoon or Tuesday morning is overpowering the fear.
My brother and niece are here from Montana to lend a hand with Luca and Dill Pickle's care and entertainment.
I am so very extremely blessed with a loving, close-knit, supportive, involved, hands-on family.
GO TEAM D!!!!!
Today, Sunday is very quiet and calm around the unit. Half of the staff are at the Kids Cancer camp that happens every spring. There are not that many staff so it seems mellow. Dill Pickle is feeling well, more energy than yesterday for sure. He is eating and beginning to crave some foods (albeit not the most healthy choices but intake is intake at this point).
Saturday, May 26, 2012
Pole Surfing
Saturday, May 26, 2012
One of the head physicians in Pediatric Oncology told Dillon and Luca, on our second day here, that he would teach them to Pole Surf.
The day passed and there was no surf lesson. The next day Luca asked me about pole surfing and he said that Dr. McKinnell had 'promised' to teach him. Well, the doc didn't come and didn't come. Luca overheard the nurses talking and he comes rushing up to me and says...."I heard that Dr. McKinnell is here, can I go find him and ask about pole surfing." I figured it was okay since the doctor HAD been the one to mention it. The hunt was on. Luca walked through the halls several times and then he finally spotted Dr. McKinnell standing and speaking with a nurse. He stood close by and waited and waited and waited. The doc finally noticed him and said, " Hey Luca, do you need something." Well Luca promptly refreshed the doctor's memory about his PROMISE to teach him and his brother how to pole surf. Dr. McKinnell's face lit up and off they went to find Dill Pickle and George.
This doctor is one of those adults who secretly wishes they were still a kid...so he imparts fun and slightly crazy, dangerous, and out-of-control activities on the kids who are hospitalized.
So the way it works is this:
The patient stands on the legs that stick out of the IV pole. They then hold onto the pole and the doctor pushes them at a full speed run down the hallway.
After Dr. McKinnell tried to take Luca around a corner and they tipped the pole over and almost ended up in a pile on the floor, the surgeon that was going to be doing D's surgery the next morning came in and gave the doc a lecture about how unsafe that activity was and that he could have caused a serious head injury to Luca. With a smirk and a laugh Dr. McKinnell teased the surgeon that he did not remember how to have fun and he needed to loosen up. It was very funny and of course the boys LOOOOVEEEEDDDD it, and love Dr. McKinnell as a result. I bet he is everyone's favorite doctor. Dillon did have the strength or energy to pole surf himself, but he had a ball watching those two crazy nuts zipping up and down the hall.
One of the head physicians in Pediatric Oncology told Dillon and Luca, on our second day here, that he would teach them to Pole Surf.
The day passed and there was no surf lesson. The next day Luca asked me about pole surfing and he said that Dr. McKinnell had 'promised' to teach him. Well, the doc didn't come and didn't come. Luca overheard the nurses talking and he comes rushing up to me and says...."I heard that Dr. McKinnell is here, can I go find him and ask about pole surfing." I figured it was okay since the doctor HAD been the one to mention it. The hunt was on. Luca walked through the halls several times and then he finally spotted Dr. McKinnell standing and speaking with a nurse. He stood close by and waited and waited and waited. The doc finally noticed him and said, " Hey Luca, do you need something." Well Luca promptly refreshed the doctor's memory about his PROMISE to teach him and his brother how to pole surf. Dr. McKinnell's face lit up and off they went to find Dill Pickle and George.
This doctor is one of those adults who secretly wishes they were still a kid...so he imparts fun and slightly crazy, dangerous, and out-of-control activities on the kids who are hospitalized.
So the way it works is this:
The patient stands on the legs that stick out of the IV pole. They then hold onto the pole and the doctor pushes them at a full speed run down the hallway.
 | ||||
| Luca Pole Surfing with Dr. McKinnell |
After Dr. McKinnell tried to take Luca around a corner and they tipped the pole over and almost ended up in a pile on the floor, the surgeon that was going to be doing D's surgery the next morning came in and gave the doc a lecture about how unsafe that activity was and that he could have caused a serious head injury to Luca. With a smirk and a laugh Dr. McKinnell teased the surgeon that he did not remember how to have fun and he needed to loosen up. It was very funny and of course the boys LOOOOVEEEEDDDD it, and love Dr. McKinnell as a result. I bet he is everyone's favorite doctor. Dillon did have the strength or energy to pole surf himself, but he had a ball watching those two crazy nuts zipping up and down the hall.
Meet George
Saturday, May 26, 2012
On our first day here (May 15) Dillon got an IV. He was very upset and it was an extremely stressful process for him.
So George is now Mr. Pickle's trusty companion.....
we might even miss him when we go home.....
OR NOT :))
On our first day here (May 15) Dillon got an IV. He was very upset and it was an extremely stressful process for him.
The first nurse we had overnight comes in and says..."Hey Dillon, who is your friend?" Dillon, always able to think on his feet, says, "Oh, that is George." And the name stuck.
 |
| Big D and George |
 |
| Look at that face!!! |
we might even miss him when we go home.....
OR NOT :))
Friday, May 25, 2012
Amazing sleep
Friday, May 25, 2012
Parents,
Do you remember that feeling you had when you would sit and just watch your baby sleep...
Do you remember that feeling you had knowing that you created or adopted this amazing little being...
Do you remember the joy that soared through your heart when your baby would smile in their sleep, and your wonder and curiosity of what they must be thinking about or imaging...
that is me, right now, at 11:43 p.m...
peaceful, sleeping, bliss
Parents,
Do you remember that feeling you had when you would sit and just watch your baby sleep...
Do you remember that feeling you had knowing that you created or adopted this amazing little being...
Do you remember the joy that soared through your heart when your baby would smile in their sleep, and your wonder and curiosity of what they must be thinking about or imaging...
that is me, right now, at 11:43 p.m...
peaceful, sleeping, bliss
Sigh.....the honeymoon is over
Friday, May 25, 2012
I actually went home yesterday because my younger son, Luca, was falling apart. That sweet boy has a burden to carry in this journey as well. As we drove home together for the first time in 10 days (which is an eternity for a 7-year-old) I asked Luca, "What are you feeling honey?"
Through teary eyes, trembling lower lip, and quivery voice...."Mama, I just really don't like not having someone to play with;" shoulders slumped over and big alligator tears began rolling down his sweet chubby wind-reddened cheeks. "I MISS MY BROTHER!!!!" Is what this heartbroken boy was trying to say. "I am scared that he will not be able to play with me ever again." Hang on little Luca...Mama is here!!!!
Yesterday (Thursday May 24) Dillon was full of piss and vinegar...as my dad would say. (My dad is known for having a saying for every occasion. :) Ornery, energetic, hungry, playful, talkative......UNTIL HE WASN'T.
Big D had to summon superhuman courage and strength because today he had to get his port access changed. The port is an implanted tube that is in his chest just under the skin. It is used to give meds, chemo, and take blood (no more needles...EXCEPT when it has to be changed out every 7th day). Oh, poor Pickle has worried about this day since BEFORE he got the surgery to place the port, and today was the day.
Image a snap...the two sides. One side is under D's skin with a tube connected to it that runs straight up and into his heart.. When the port is not accessed there is just a bump under his skin...the flat 'snap' that is implanted. When the port is accessed, they put the other half of the snap on, which contains a needle in the middle on the side that touches the skin, which fits into the tube that is in the middle of the 'snap' imbedded in Big D's chest and the back side has a tube, which is used for blood draws, IV line, and medication administration.
The descent began with the nurse removing the first access to the port. He was giddy, elated...FREE!!! He ran a little without his pole. He showered for the first time in days. He stayed in that shower just groaning about how good the hot water felt running over his skin. Then reality set in. The nurse came in to put on a blob of numbing cream or magic cream as some of the nurses call it. It numbs the surface of the skin so he would not feel the small needle poke when they re-place the port. Well, his anxiety started as soon as that cream was on. He began by being quiet and withdrawn. Anne Contreras (a classmate's mother) came bearing gifts; Carol and Gail from Pro Musica came and played him some beautiful music. As the songs wore on, he became more anxious. He began hyperventilating and getting tingling arms and legs (lack of oxygen). He trembled a bit and finally...he threw up. Our brave and ever powerful D was crumbling under the pressure and fear of the pain of that darn needle stick.
In comes the nurse with the port access. He turns white, he trembles (his Nana talks him through it with a beautiful and fun visualization of his boating trip about a month ago to Elephant Butte)....and ...and....and......
"THAT'S IT??????? Wow, that was not so bad!!"
Today Dillon learned that his mind is a very powerful tool in the fear factor. He learned that he can get himself worked up emotionally and physically just by worrying. He also learning that by keeping his mind busy during stressful times that it goes a lot easier than it might otherwise.
Note to self.....practice visualization cues and stories to help BIG D cope with his fear of pain.
Friday, May 25, 2012 (day 6 in the treatment protocol...day 1 was his first chemo treatment)
Vomit, medication, sleep....REPEAT. That is pretty much a summary of Dillon's day today. Everyone was surprised by how good he looked, how well he was eating, how much energy he had after chemotherapy on Sunday....well that honeymoon is OVER. The nurses said, oh yeah sometimes it takes 5 or 6 days for the side effects...well today was day 6. Right on schedule. Poor D is so incredibly terribly horribly miserable today...all day from dawn until dark.
What a helpless feeling....my sweet boy staring into my eyes as he rouses from a medication-induced sleep..not saying a word, no facial expression...just staring, unblinking. Those eyes were screaming at me...."MAMA, PLEASE MAKE THIS STOP, PLEASE MAKE IT GO AWAY, PLEASE DO SOMETHING, ANYTHING TO FIX THIS!!!!!"
Oh my baby boy, how I wish I could...how I wish it were me and not you...how I wish I could do something, anything to ease your discomfort even just a little. The best I can offer you sweet boy, are my eyes to stare into, my hand to hold, and my everlasting undying love and admiration for you.
I actually went home yesterday because my younger son, Luca, was falling apart. That sweet boy has a burden to carry in this journey as well. As we drove home together for the first time in 10 days (which is an eternity for a 7-year-old) I asked Luca, "What are you feeling honey?"
Through teary eyes, trembling lower lip, and quivery voice...."Mama, I just really don't like not having someone to play with;" shoulders slumped over and big alligator tears began rolling down his sweet chubby wind-reddened cheeks. "I MISS MY BROTHER!!!!" Is what this heartbroken boy was trying to say. "I am scared that he will not be able to play with me ever again." Hang on little Luca...Mama is here!!!!
Yesterday (Thursday May 24) Dillon was full of piss and vinegar...as my dad would say. (My dad is known for having a saying for every occasion. :) Ornery, energetic, hungry, playful, talkative......UNTIL HE WASN'T.
Big D had to summon superhuman courage and strength because today he had to get his port access changed. The port is an implanted tube that is in his chest just under the skin. It is used to give meds, chemo, and take blood (no more needles...EXCEPT when it has to be changed out every 7th day). Oh, poor Pickle has worried about this day since BEFORE he got the surgery to place the port, and today was the day.
Image a snap...the two sides. One side is under D's skin with a tube connected to it that runs straight up and into his heart.. When the port is not accessed there is just a bump under his skin...the flat 'snap' that is implanted. When the port is accessed, they put the other half of the snap on, which contains a needle in the middle on the side that touches the skin, which fits into the tube that is in the middle of the 'snap' imbedded in Big D's chest and the back side has a tube, which is used for blood draws, IV line, and medication administration.
The descent began with the nurse removing the first access to the port. He was giddy, elated...FREE!!! He ran a little without his pole. He showered for the first time in days. He stayed in that shower just groaning about how good the hot water felt running over his skin. Then reality set in. The nurse came in to put on a blob of numbing cream or magic cream as some of the nurses call it. It numbs the surface of the skin so he would not feel the small needle poke when they re-place the port. Well, his anxiety started as soon as that cream was on. He began by being quiet and withdrawn. Anne Contreras (a classmate's mother) came bearing gifts; Carol and Gail from Pro Musica came and played him some beautiful music. As the songs wore on, he became more anxious. He began hyperventilating and getting tingling arms and legs (lack of oxygen). He trembled a bit and finally...he threw up. Our brave and ever powerful D was crumbling under the pressure and fear of the pain of that darn needle stick.
 |
| Sean and Nana listening to Gail and Carol |
 |
| Carol (in black, Dillon's CHAMPs coach) and Gail (the head of Santa Fe ProMusica) |
 |
| Dillon trying to enjoy the music, but so very very nervous |
In comes the nurse with the port access. He turns white, he trembles (his Nana talks him through it with a beautiful and fun visualization of his boating trip about a month ago to Elephant Butte)....and ...and....and......
"THAT'S IT??????? Wow, that was not so bad!!"
Today Dillon learned that his mind is a very powerful tool in the fear factor. He learned that he can get himself worked up emotionally and physically just by worrying. He also learning that by keeping his mind busy during stressful times that it goes a lot easier than it might otherwise.
Note to self.....practice visualization cues and stories to help BIG D cope with his fear of pain.
Friday, May 25, 2012 (day 6 in the treatment protocol...day 1 was his first chemo treatment)
Vomit, medication, sleep....REPEAT. That is pretty much a summary of Dillon's day today. Everyone was surprised by how good he looked, how well he was eating, how much energy he had after chemotherapy on Sunday....well that honeymoon is OVER. The nurses said, oh yeah sometimes it takes 5 or 6 days for the side effects...well today was day 6. Right on schedule. Poor D is so incredibly terribly horribly miserable today...all day from dawn until dark.
What a helpless feeling....my sweet boy staring into my eyes as he rouses from a medication-induced sleep..not saying a word, no facial expression...just staring, unblinking. Those eyes were screaming at me...."MAMA, PLEASE MAKE THIS STOP, PLEASE MAKE IT GO AWAY, PLEASE DO SOMETHING, ANYTHING TO FIX THIS!!!!!"
Oh my baby boy, how I wish I could...how I wish it were me and not you...how I wish I could do something, anything to ease your discomfort even just a little. The best I can offer you sweet boy, are my eyes to stare into, my hand to hold, and my everlasting undying love and admiration for you.
Tuesday, May 22, 2012
Helicopter coming at the window
Tuesday, May 22, 2012
So Dillon had another uneventful day. Very similar to yesterday...so I am gonna talk about something else tonight.
The HELICOPTER. We have all seen the Life Flight chopper speeding around, and if you are at all like me, I always feel wonder at the technology of that system and then deep sadness and fear for whoever is inside.
The other night Dillon and Sean were sitting in the hospital room and suddenly heard the helicopter. Dillon loves helicopters and actually has one that he flies. Sean's Dad has flown RC helicopters for years and he is now teaching Big D about this hobby..now that he is 10 and can handle the technical aspects of helicopter flight. SOOOO this was pretty exciting . They rush over to the window and out of the sky suddenly appears the Life Flight chopper....heading straight for the window (or so it seemed to Big D).
Turns out the landing pad is right above us. We are on the 6th floor which is the top floor of UNM Children's but seriously the pad is above our room...well okay not RIGHT above, it is probably 20 feet over because right above would be on the very edge of the building...but still.....
So everyday the Life Flight comes in multiple times.....Dillon and I marvel at it flying straight at us and then suddenly...seemingly at the last minute.....above us. We hear and feel it land. We feel it stop running. We wait....wait...wait....and then we feel and hear it start up again and you can actually feel when it takes off, that instant when it is airborne, we can feel that and hear that. There is a change in the vibration and the sound of the rotors. It is really super cool.......HOWEVER
We sit and discuss during the time that we wait for takeoff, who must be in that helicopter, how scared and hurt they must be. We discuss wishing them well and fast healing and hope that they have family waiting for them inside the hospital . Remember, we are at the Children's Hospital so every single time that Life Flight lands, it is a child in dire need.
Dillon is also able to discuss his gratitude for where he is at in life. Of course he does....that is classic Dillon. He can say...at least I was not so sick to have to come in the helicopter all by my self. At least I can walk around and smile and talk and eat and some kids can't. One child has one arm here on the floor and he is so grateful that he has 2 arms and can do as he pleases with both of them. He also as the utmost sympathy. He feels badly for the kids that are here. I don't know if he does not see himself as one of them or if the is just so profoundly intuitive to know that they might be worse off than he and he is sad for them and their families for that.
So that is today's story. Sleep sweetly and we will see you tomorrow!!
So Dillon had another uneventful day. Very similar to yesterday...so I am gonna talk about something else tonight.
The HELICOPTER. We have all seen the Life Flight chopper speeding around, and if you are at all like me, I always feel wonder at the technology of that system and then deep sadness and fear for whoever is inside.
The other night Dillon and Sean were sitting in the hospital room and suddenly heard the helicopter. Dillon loves helicopters and actually has one that he flies. Sean's Dad has flown RC helicopters for years and he is now teaching Big D about this hobby..now that he is 10 and can handle the technical aspects of helicopter flight. SOOOO this was pretty exciting . They rush over to the window and out of the sky suddenly appears the Life Flight chopper....heading straight for the window (or so it seemed to Big D).
Turns out the landing pad is right above us. We are on the 6th floor which is the top floor of UNM Children's but seriously the pad is above our room...well okay not RIGHT above, it is probably 20 feet over because right above would be on the very edge of the building...but still.....
So everyday the Life Flight comes in multiple times.....Dillon and I marvel at it flying straight at us and then suddenly...seemingly at the last minute.....above us. We hear and feel it land. We feel it stop running. We wait....wait...wait....and then we feel and hear it start up again and you can actually feel when it takes off, that instant when it is airborne, we can feel that and hear that. There is a change in the vibration and the sound of the rotors. It is really super cool.......HOWEVER
We sit and discuss during the time that we wait for takeoff, who must be in that helicopter, how scared and hurt they must be. We discuss wishing them well and fast healing and hope that they have family waiting for them inside the hospital . Remember, we are at the Children's Hospital so every single time that Life Flight lands, it is a child in dire need.
Dillon is also able to discuss his gratitude for where he is at in life. Of course he does....that is classic Dillon. He can say...at least I was not so sick to have to come in the helicopter all by my self. At least I can walk around and smile and talk and eat and some kids can't. One child has one arm here on the floor and he is so grateful that he has 2 arms and can do as he pleases with both of them. He also as the utmost sympathy. He feels badly for the kids that are here. I don't know if he does not see himself as one of them or if the is just so profoundly intuitive to know that they might be worse off than he and he is sad for them and their families for that.
So that is today's story. Sleep sweetly and we will see you tomorrow!!
Monday, May 21, 2012
Dillon is better than ever today
Monday, May 21, 2012
Dill Pickle ate more today than he has in days; a pint of raspberries for breakfast, lots of water, juice, mac & cheese, crackers, oranges, and countless other bites of stuff. He was constantly looking at other people's food and saying...."Can I taste that??" It was so funny because he was so comical about it.
BIG D has been in high spirits...almost giddy most of the day. It is really interesting to me. He is fully taking in and processing all this information, as we all are, and he is starting to just accept the situation, put his head down, and charge through...TRUE Dillon fashion (a task needs doing...he is on it).
With that positive note....we have added a DONATION BUTTON to this blog. The medical bills are going to be astronomical and we have less than mediocre insurance.
If you have been wondering what you could possibly do to help boost this family...that button is the fast, easy, and powerful answer.
Dill Pickle ate more today than he has in days; a pint of raspberries for breakfast, lots of water, juice, mac & cheese, crackers, oranges, and countless other bites of stuff. He was constantly looking at other people's food and saying...."Can I taste that??" It was so funny because he was so comical about it.
BIG D has been in high spirits...almost giddy most of the day. It is really interesting to me. He is fully taking in and processing all this information, as we all are, and he is starting to just accept the situation, put his head down, and charge through...TRUE Dillon fashion (a task needs doing...he is on it).
With that positive note....we have added a DONATION BUTTON to this blog. The medical bills are going to be astronomical and we have less than mediocre insurance.
If you have been wondering what you could possibly do to help boost this family...that button is the fast, easy, and powerful answer.
Spread the word. The more folks that see the blog, pray for Dillon, and press that donate button, the better his and our family's outcome will be.
Sunday, May 20, 2012
Blood is SO very important
Sunday, May 20, 2012
We learned yesterday that Dillon will be getting lots of different transfusions during this process; from packed red blood cells to platelets, and other various concoctions.
This is a call of duty for all of us.
DONATE BLOOD!!!!!
No, Dillon will not get your blood, but someone's child or dad or sister or grandparent will...and without it their treatments will not be successful and thus, life is cut short.
Help us save all the kids with cancer by having the resources they need available, and the one we can help with is the blood.
We learned yesterday that Dillon will be getting lots of different transfusions during this process; from packed red blood cells to platelets, and other various concoctions.
This is a call of duty for all of us.
DONATE BLOOD!!!!!
No, Dillon will not get your blood, but someone's child or dad or sister or grandparent will...and without it their treatments will not be successful and thus, life is cut short.
Help us save all the kids with cancer by having the resources they need available, and the one we can help with is the blood.
We have a diagnosis...
Sunday, May 20, 2012
Today Dillon did much better than yesterday physically and emotionally. He had a few visitors...which he loves. A change of scenery, as far as who is in the room, is a big mood lifter for him.
Big D's 'other grandparents' came down. Sean's folks are here from Colorado for a few days, which gives Dillon much love and needed distraction, as well as a break for my parents on the front of taking care of Mr. Luca (who by the way is being the best brother ever...as usual. He is appropriately concerned and worried but still mischievous and happy and busy as we all know him to be).
Dillon finally ate last night...half a hamburger and a handful of fries, followed by 2 or 3 cups of water, which is more than he has eaten in days. YEAH DILLON!!!!!!
Okay, enough chit chat.....I know you are all holding your breath for the name of this thing in our boy's chest.
I even knew how to spell if from my previous 11 years of medical transcribing. It seems I have been preparing for all of this medical jargon since my baby boy was in my belly.
A word of advice/caution....IF you choose to go on the internet to look for more information on the monster growing in D's body...you MUST look for pediatric or childhood. The treatments, outcomes, prognosis, EVERYTHING is different between kids and adults. So don't go reading all the adult stuff and freak yourself out !!! :)
Some details...we caught this relatively early. YEAH DILLON for telling us about the strange feeling in your neck!! They did find some of the lymphoma in his bone marrow. Yes yes that is bad...but it could be worse. He had 1.5% of his bone marrow cells show up as lymphoma. The doctor said some kids with other cancers some in with 80% or even 100% of the bone marrow being cancer cells...so 1.5% is obviously better than that...however not as good as 0%..OBVIOUSLY. The other thing is that there were NO cells in his CSF (cerebral spinal fluid with is the fluid that surrounds the brain and spinal cord). So that too is a positive thing!!!
The mass behind in BIG D's chest is approximately 1.2 x 2.5 inches...which in the doctor's words is SUBSTANTIAL. Sounds pretty small to me (wink wink). Haven't we all heard of people with grapefruit-sized masses???
Okay, now the treatment. We start today (May 20). It is a 29 day treatment cycle. He will be getting a whole list of various chemotherapy drugs along with some other things to counteract the toxicity and side effects of the chemo drugs. The treatments are approximately once a week with some other stuff sprinkled in between and much lab work and other testing to make sure all of his levels (white blood cell count, platelets, red blood cell count, electrolytes, blood sugars, etc) are within normal limits. If they are not, there are treatments to augment the fallout from the tumor breaking down in his body and the chemo killing off good cells, as well as bad.
Yes he will be bald.
Yes he will be nauseous.
Yes he will be weak.
Yes he will lose weight.
NO WE ARE NOT GONNA LET THIS THING BEAT US!!!!!!
Today Dillon did much better than yesterday physically and emotionally. He had a few visitors...which he loves. A change of scenery, as far as who is in the room, is a big mood lifter for him.
Big D's 'other grandparents' came down. Sean's folks are here from Colorado for a few days, which gives Dillon much love and needed distraction, as well as a break for my parents on the front of taking care of Mr. Luca (who by the way is being the best brother ever...as usual. He is appropriately concerned and worried but still mischievous and happy and busy as we all know him to be).
Dillon finally ate last night...half a hamburger and a handful of fries, followed by 2 or 3 cups of water, which is more than he has eaten in days. YEAH DILLON!!!!!!
Okay, enough chit chat.....I know you are all holding your breath for the name of this thing in our boy's chest.
T-CELL LYMPHOBLASTIC LYMPHOMA
One of DIllon's first questions when he came out of surgery was...."Can I see the lymph nodes?" The surgeon told him that it was not possible to see the actual lymph nodes but that he could try to get photos of the slides from the lab where the biopsy analysis was taking place. Dillon was satisfied with that and wanted you all to see what the monster growing in his neck looks like under a microscope.
One of DIllon's first questions when he came out of surgery was...."Can I see the lymph nodes?" The surgeon told him that it was not possible to see the actual lymph nodes but that he could try to get photos of the slides from the lab where the biopsy analysis was taking place. Dillon was satisfied with that and wanted you all to see what the monster growing in his neck looks like under a microscope.
I even knew how to spell if from my previous 11 years of medical transcribing. It seems I have been preparing for all of this medical jargon since my baby boy was in my belly.
A word of advice/caution....IF you choose to go on the internet to look for more information on the monster growing in D's body...you MUST look for pediatric or childhood. The treatments, outcomes, prognosis, EVERYTHING is different between kids and adults. So don't go reading all the adult stuff and freak yourself out !!! :)
Some details...we caught this relatively early. YEAH DILLON for telling us about the strange feeling in your neck!! They did find some of the lymphoma in his bone marrow. Yes yes that is bad...but it could be worse. He had 1.5% of his bone marrow cells show up as lymphoma. The doctor said some kids with other cancers some in with 80% or even 100% of the bone marrow being cancer cells...so 1.5% is obviously better than that...however not as good as 0%..OBVIOUSLY. The other thing is that there were NO cells in his CSF (cerebral spinal fluid with is the fluid that surrounds the brain and spinal cord). So that too is a positive thing!!!
The mass behind in BIG D's chest is approximately 1.2 x 2.5 inches...which in the doctor's words is SUBSTANTIAL. Sounds pretty small to me (wink wink). Haven't we all heard of people with grapefruit-sized masses???
Okay, now the treatment. We start today (May 20). It is a 29 day treatment cycle. He will be getting a whole list of various chemotherapy drugs along with some other things to counteract the toxicity and side effects of the chemo drugs. The treatments are approximately once a week with some other stuff sprinkled in between and much lab work and other testing to make sure all of his levels (white blood cell count, platelets, red blood cell count, electrolytes, blood sugars, etc) are within normal limits. If they are not, there are treatments to augment the fallout from the tumor breaking down in his body and the chemo killing off good cells, as well as bad.
Yes he will be bald.
Yes he will be nauseous.
Yes he will be weak.
Yes he will lose weight.
NO WE ARE NOT GONNA LET THIS THING BEAT US!!!!!!
Friday, May 18, 2012
Days 2, 3 and 4 the poking and proding continue
Day 2, Wednesday, May 16, 2012:
Today Dillon got a PET/CT scan. They injected him with radioactive sugar to 'light up' any active growing tumors and to identify any more tumors that are yet unknown. Also they take cross-section cut pictures of his entire torso to be able to see exactly where all the tumors are and how big they are. He 'performed' like a champ and was happy the procedure did not hurt.
Sean and Luca came this morning. We did not tell them about the cancer last night....we wanted to tell them in person. Sean and I had to leave the room and cry and hold each other. Dillon and Luca do not understand. They know it is bad, because he is in the hospital...but they don't know the gravity, the seriousness, the dangers, the treatments, the outcomes. Those silly boys just hung out on the bed, walked around, played video games, laughed, and talked.
Day 3, Thursday, May 17, 2012:
Today was surgery day. Dillon was very brave but obviously scared (most of the pain). He got procedures done today by 2 different surgical teams. The first team took the lymph node biopsy from the mass on the left side of his neck and then they placed a port in his chest, also known as a central line. It is a way to draw blood and give meds, including the upcoming chemo. The second set of surgeons was the oncology team and they took a bone marrow biopsy and they did a spinal tap or lumbar puncture, which included injecting a prophylactic (preventative) dose of chemo into the cervical spinal fluid that surrounds the brain and spinal cord.
He was in surgery for over 3 hours and, needless to say, the rest of the day and evening was full of dizziness, nausea, and a fair amount of pain and stiffness. He was relieved to be rid of the IV, but he was disappointed that the port hurt so much. Waiting 2 days for it to be less sore just feels like an eternity to him.
Day 4, Friday, May 18, 2012:
We were hoping for biopsy results today, which will give us the exact diagnosis (what type of lymphoma this is) and the treatment protocol (what treatment, how long, how often, etc). Nope. None of that happened today. Still waiting on pathology. Today was full of rest. Dillon hardly got out of bed. He did have some excitement. Finn came by and provided some entertainment....which they both enjoyed a lot. My dad also spent several hours playing basketball on the Wii (yes D has a Wii in his room...if you gotta be sick, this is the place to do it :)) and I worked on my laptop in a conference room down the hall.
A meeting is scheduled with the entire oncology and surgical team for tomorrow at 3 p.m. They will have the diagnosis and we will talk about and begin treatment.
Until then.....
Today Dillon got a PET/CT scan. They injected him with radioactive sugar to 'light up' any active growing tumors and to identify any more tumors that are yet unknown. Also they take cross-section cut pictures of his entire torso to be able to see exactly where all the tumors are and how big they are. He 'performed' like a champ and was happy the procedure did not hurt.
 |
| That's a lot of labs!! |
 |
| This nurse was sweet, kind, and gentle. |
 |
| Two dudes hanging in a hospital bed. Luca's first visit. |
Day 3, Thursday, May 17, 2012:
Today was surgery day. Dillon was very brave but obviously scared (most of the pain). He got procedures done today by 2 different surgical teams. The first team took the lymph node biopsy from the mass on the left side of his neck and then they placed a port in his chest, also known as a central line. It is a way to draw blood and give meds, including the upcoming chemo. The second set of surgeons was the oncology team and they took a bone marrow biopsy and they did a spinal tap or lumbar puncture, which included injecting a prophylactic (preventative) dose of chemo into the cervical spinal fluid that surrounds the brain and spinal cord.
He was in surgery for over 3 hours and, needless to say, the rest of the day and evening was full of dizziness, nausea, and a fair amount of pain and stiffness. He was relieved to be rid of the IV, but he was disappointed that the port hurt so much. Waiting 2 days for it to be less sore just feels like an eternity to him.
 |
| Recovering from the port placement and lymph node biopsy |
Day 4, Friday, May 18, 2012:
We were hoping for biopsy results today, which will give us the exact diagnosis (what type of lymphoma this is) and the treatment protocol (what treatment, how long, how often, etc). Nope. None of that happened today. Still waiting on pathology. Today was full of rest. Dillon hardly got out of bed. He did have some excitement. Finn came by and provided some entertainment....which they both enjoyed a lot. My dad also spent several hours playing basketball on the Wii (yes D has a Wii in his room...if you gotta be sick, this is the place to do it :)) and I worked on my laptop in a conference room down the hall.
 |
| Best Friends (Finn got here as soon as he could!) |
 |
| Grampy hanging with Dillon and eating chocolate ice cream |
A meeting is scheduled with the entire oncology and surgical team for tomorrow at 3 p.m. They will have the diagnosis and we will talk about and begin treatment.
Until then.....
Hey, what is that on your neck?
Most of you are here because you already know that Dillon has cancer. But I get a lot of questions, especially from worried moms, about how we "found it." So I am going to start our blog from the point of when we decided that something might be wrong with BIG D.
About 2 weeks ago (sometime in early May) Dillon complained of a lump on his neck, in front of his collarbone. It was firm and a little tender and on the left. Dillon had been playing a lot of basketball and had been training for his pentathlon at school, so Sean and I decided it was probably a muscle strain/pull of some sort. He did not complain about it any more....so we went along our merry little lives.
Then, on May 14 Dillon came home from school saying that he now had a lump on the other side (the right) in the same location as the left side, and it was quite tender. By evening it was downright painful, and by morning he could not get out of bed unassisted because it hurt his neck whenever he moved his body. Well, I decided that was just a bit to severe to be a simple muscle issue, and why would the muscle be swelling and lumping up in the same location on both sides. Sean expressed great concern on the evening of May 14, which is very unlike him. He is more of the wait and see kind of dad, which is usually the appropriate protocol with young active boys (one day they are in pain over something and then next they are miraculous healed :)
On the morning of Tuesday, May 15, I dropped Luca off at school and proceeded to call Arroyo Chamiso Pediatrics to set up a visit for that day. Dillon was in so much discomfort that he informed me that he would not be attending school that day; so we set off for the doctor's office after securing a same-day appointment for 9 a.m.
Dillon was seen by a new doctor at Arroyo Chamiso that we had never met; Aja Sanzone, MD. She examined D for a couple of minutes and said she wanted to go get our 'regular doctor' for a second look. In came Dr. Edward Kleiner to examine Dillon. He agreed with Dr. Sanzone's assessment, which was that this was clearly a lymph node swelling (thus the masses on both sides in the same location) and that they were in a very unusual location. She informed us that she would be calling UNM in Albuquerque and that she wanted us to be seen there. Okay, I am thinking....a referral that we will deal with in a few weeks...isn't that how referrals usually work? At that point she informed me that indeed it was a referral and they would be waiting for us immediately at the inpatient unit at UNM Children's Hospital. Inpatient....WHAT...I thought to myself . Why on earth would we be going to an inpatient unit for a quick little referral. NO, the panic had not set in yet. I was still processing and assuming it was yet another one of those referrals where you go all over the place, get tests, and then guess what, you are fine. I really was not too worried or scared at this point. They told us when we got to UNM we would have some labs and tests done. Okay, easy enough.
Big D and I went home, called Sean, and packed a bag with snacks and books and stuff. We drove to Albuquerque and decided we were hungry, so we stopped for lunch. When we got to UNM Children's Hospital we finally found the building we needed to be in and headed up to the 6th floor. It turns out the sign said Pediatric Special Care Unit....okay I am thinking...this is getting weird. Why on earth do we need to be going to a special care unit??? We walked in and they had a bed waiting, they knew who we were and why we were there...YIKES!!! So we sat around the room for a few minutes and a nurses came in to inform us that there was lab work and x-rays ordered. No paperwork, not signing stuff, no giving over a copy of the insurance card...just straight to tests. When D heard the words lab work he knew immediately that meant NEEDLES!!!! OH PANIC. It took a lot of cajoling, consoling, convincing, and tear wiping to get through the lab draw, which ended up, after 3 tries, with the blood they needed and an IV in place...just in case...they said. "Just in case what????" I am thinking in the back of my mind. Now down for the x-ray, which was easy and fast and to Big D's delight...did not involve any more needles.
Now....WAITING WAITING WAITING..... watching basketball in a hospital room in the early evening on May 15. Dillon got a food tray with a burger and fries and the nurse sneaked him a coke (hey he says, this place is fun). We got to go outside to the play area that is on the 6th floor of the hospital. There was a band out there performing for the kids.
It is now early evening and in comes the entourage....5 doctors (two of which were medical students) with the head of the group being Dr. McKinnell of Pediatric Oncology. Okay, now I start to panic. The doctor jokes around with D for a while about his burger and coke and the basketball game. They chat about the Celtics and the fact that Dillon has not been sick AT ALL the past few weeks (other than his usual seasonal allergies) and that he learned to throw a javelin and discus at school for the Greek pentathlon. Then the doctor turns to me...I am nervous, shallow breathing....."There is a mass in your son's chest." A WHAT....is screaming through my head. I start to shake a little and reach for Dillon's hand...which is also shaking a bit. He pushes his food tray away. The doctor goes on....it is MOST DEFINITELY malignant.....WHAT.....is screaming in my head again. The female med student tears up as I meet her eyes and she has to turn away. Dillon is breathing fast...having no idea what malignant means but knowing full well a room full of doctors and a mass in his chest has got to be something bad.
The doctor goes on to describe the mass a bit, why he knows it is malignant (because of the location and Dillon's symptoms...it is apparently always malignant in these situations), and what the next step is. We ask a few questions, which I cannot recall at this point, and the doctors leave.
I turn to my sweet little boy and I say..."You are sick bubba." And he whispers..."I know."
He climbs into my lap and we cry. He has not clutched onto me or held me that tight or for that long in years.
My poor baby boy has cancer.....
About 2 weeks ago (sometime in early May) Dillon complained of a lump on his neck, in front of his collarbone. It was firm and a little tender and on the left. Dillon had been playing a lot of basketball and had been training for his pentathlon at school, so Sean and I decided it was probably a muscle strain/pull of some sort. He did not complain about it any more....so we went along our merry little lives.
Then, on May 14 Dillon came home from school saying that he now had a lump on the other side (the right) in the same location as the left side, and it was quite tender. By evening it was downright painful, and by morning he could not get out of bed unassisted because it hurt his neck whenever he moved his body. Well, I decided that was just a bit to severe to be a simple muscle issue, and why would the muscle be swelling and lumping up in the same location on both sides. Sean expressed great concern on the evening of May 14, which is very unlike him. He is more of the wait and see kind of dad, which is usually the appropriate protocol with young active boys (one day they are in pain over something and then next they are miraculous healed :)
On the morning of Tuesday, May 15, I dropped Luca off at school and proceeded to call Arroyo Chamiso Pediatrics to set up a visit for that day. Dillon was in so much discomfort that he informed me that he would not be attending school that day; so we set off for the doctor's office after securing a same-day appointment for 9 a.m.
Dillon was seen by a new doctor at Arroyo Chamiso that we had never met; Aja Sanzone, MD. She examined D for a couple of minutes and said she wanted to go get our 'regular doctor' for a second look. In came Dr. Edward Kleiner to examine Dillon. He agreed with Dr. Sanzone's assessment, which was that this was clearly a lymph node swelling (thus the masses on both sides in the same location) and that they were in a very unusual location. She informed us that she would be calling UNM in Albuquerque and that she wanted us to be seen there. Okay, I am thinking....a referral that we will deal with in a few weeks...isn't that how referrals usually work? At that point she informed me that indeed it was a referral and they would be waiting for us immediately at the inpatient unit at UNM Children's Hospital. Inpatient....WHAT...I thought to myself . Why on earth would we be going to an inpatient unit for a quick little referral. NO, the panic had not set in yet. I was still processing and assuming it was yet another one of those referrals where you go all over the place, get tests, and then guess what, you are fine. I really was not too worried or scared at this point. They told us when we got to UNM we would have some labs and tests done. Okay, easy enough.
Big D and I went home, called Sean, and packed a bag with snacks and books and stuff. We drove to Albuquerque and decided we were hungry, so we stopped for lunch. When we got to UNM Children's Hospital we finally found the building we needed to be in and headed up to the 6th floor. It turns out the sign said Pediatric Special Care Unit....okay I am thinking...this is getting weird. Why on earth do we need to be going to a special care unit??? We walked in and they had a bed waiting, they knew who we were and why we were there...YIKES!!! So we sat around the room for a few minutes and a nurses came in to inform us that there was lab work and x-rays ordered. No paperwork, not signing stuff, no giving over a copy of the insurance card...just straight to tests. When D heard the words lab work he knew immediately that meant NEEDLES!!!! OH PANIC. It took a lot of cajoling, consoling, convincing, and tear wiping to get through the lab draw, which ended up, after 3 tries, with the blood they needed and an IV in place...just in case...they said. "Just in case what????" I am thinking in the back of my mind. Now down for the x-ray, which was easy and fast and to Big D's delight...did not involve any more needles.
 |
| The first IV |
 |
| D very tired and uncomfortable after IV placement |
Now....WAITING WAITING WAITING..... watching basketball in a hospital room in the early evening on May 15. Dillon got a food tray with a burger and fries and the nurse sneaked him a coke (hey he says, this place is fun). We got to go outside to the play area that is on the 6th floor of the hospital. There was a band out there performing for the kids.
 |
| Waiting for results, enjoying the sun and the music |
 |
| View off the 6th floor play area |
 |
| View off the 6th floor play area |
 |
| A band was entertaining the kids |
It is now early evening and in comes the entourage....5 doctors (two of which were medical students) with the head of the group being Dr. McKinnell of Pediatric Oncology. Okay, now I start to panic. The doctor jokes around with D for a while about his burger and coke and the basketball game. They chat about the Celtics and the fact that Dillon has not been sick AT ALL the past few weeks (other than his usual seasonal allergies) and that he learned to throw a javelin and discus at school for the Greek pentathlon. Then the doctor turns to me...I am nervous, shallow breathing....."There is a mass in your son's chest." A WHAT....is screaming through my head. I start to shake a little and reach for Dillon's hand...which is also shaking a bit. He pushes his food tray away. The doctor goes on....it is MOST DEFINITELY malignant.....WHAT.....is screaming in my head again. The female med student tears up as I meet her eyes and she has to turn away. Dillon is breathing fast...having no idea what malignant means but knowing full well a room full of doctors and a mass in his chest has got to be something bad.
The doctor goes on to describe the mass a bit, why he knows it is malignant (because of the location and Dillon's symptoms...it is apparently always malignant in these situations), and what the next step is. We ask a few questions, which I cannot recall at this point, and the doctors leave.
I turn to my sweet little boy and I say..."You are sick bubba." And he whispers..."I know."
He climbs into my lap and we cry. He has not clutched onto me or held me that tight or for that long in years.
My poor baby boy has cancer.....
Subscribe to:
Posts (Atom)